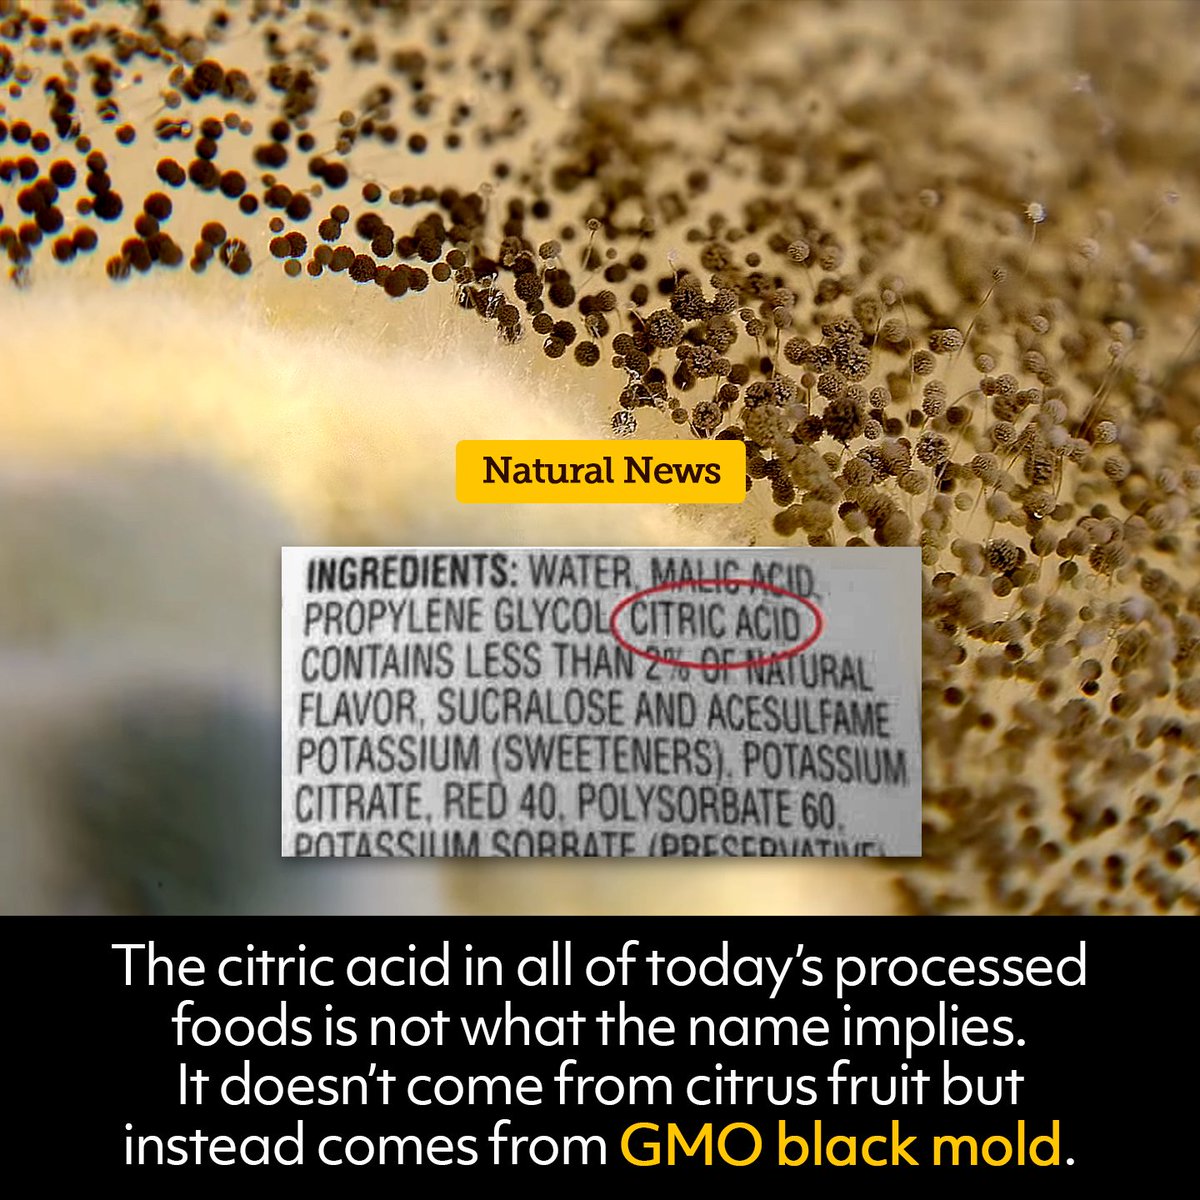
HealthRanger's tweet image. Be informed. #citricacid #health #GMO

ReadyToWin
@ReadyToWin1
👵🏼missing the old days....📞📺
You might like
Don’t close all our parks or campgrounds. There are approximately 1 million people who live full-time in an RV. Full-Time RVers Need Somewhere to Shelter-in-Place | Campendium campendium.com/camping/full-t…
#Walkaway is marching in Washington and getting zero news coverage... share this tweet far and wide!

What do they fear most? Loss of control MSM is dead Social media dictates the news cycle You have a voice Use it Sheep no more
ALERT! Domestic Threat - Communist Donor Steve Phillips Phillips is financing FOUR radical governors who were hand-picked to unite progressives to incite a communist revolution in America Ben Jealous: Maryland Andrew Gillum: Florida Stacey Abrams: Georgia David Garcia: Arizona
got a cough/sinus that you just cant seem to shake? Yeah so does everyone else #OpChemPBA #Environment


RETWEET to congratulate Andrea Lampley from Wauchula for claiming a $500,000 top prize from the EXTRA PLAY Scratch-Off game! 👏👏👏

Just saw this on my pal Ole Dammegard's Patreon page. I wish to God we had never allowed our oldest two sons get ANY vaccine, ever. #Autism #CDCknew #Aspergers

New post Let's See Them Bury THIS! (MAKE IT VIRAL FOLKS!) has been published on SGT Report - bit.ly/2MZE0WM

Incriminating documents reveal Monsanto knew they were poisoning the environment with their PCBs. bit.ly/2LioDU4 #Monsanto #health
A prominent #MeToo activist and Harvey Weinstein accuser recently agreed to pay $380,000 to settle a sexual assault complaint against her, according to a new report. ajc.com/entertainment/…
ajc.com
Asia Argento, #MeToo activist, settled sex assault claim against her, report says
A prominent #MeToo activist and Harvey Weinstein accuser recently agreed to pay $380,000 to settle a sexual assault complaint against her, according to a new report.
Stop eating. Anything but what you grow. This is criminal. So Bayer buys Monsanto, so they can “cure” you when you get sick after eating food treated with their chemicals or eat their modified seeds. It’s time we take our food back. usatoday.com/story/news/nat… PS- no amount is “safe”
United States Trends
- 1. Jasper Johnson N/A
- 2. Another ICE N/A
- 3. Good Saturday N/A
- 4. Jose Ramirez N/A
- 5. #saturdaymorning N/A
- 6. Gigi N/A
- 7. #Caturday N/A
- 8. Travis Perry N/A
- 9. MetLife N/A
- 10. The Discombobulator N/A
- 11. Marmoush N/A
- 12. #วิวาห์ปฐพีตอนที่1 N/A
- 13. Burnley N/A
- 14. Governor Carney N/A
- 15. #NattyMerch N/A
- 16. Jim Jones N/A
- 17. WELCOME TO OUR FARM N/A
- 18. Canada with 100% N/A
- 19. #SaturdayVibes N/A
- 20. Rod Stewart N/A
Something went wrong.
Something went wrong.